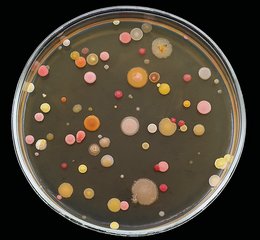

Bakterier slås om pladsen i en biofilm
Rigtig mange faktorer har betydning, når bakterier danner biofilm på for eksempel implantater, i fermenteringstanke eller i vores lunger og tarme. Biologi spiller selvfølgelig en stor rolle, men det gør fysik også. Forsker tager os med ind i bakteriernes mikroskopiske verden og belyser den rolle, som fysik har for deres liv i en biofilm.
Af Kristian Sjøgren
Overalt i verden danner bakterier biofilm, som sætter sig på overflader som et lille biologisk lag. Det kan være i menneskekroppen, hvor bakterier danner biofilm på tarmvæggen eller på indersiden af vores lunger. Nogle af disse biofilmlag kan være skadelige, men andre gange er bakterierne i biofilmene faktisk gavnlige for os. Det kan også dreje sig om biofilmdannelse på medicinsk udstyr som katetre eller pacemakere. Det er næsten altid et dårligt tegn.
Biofilm kan også blive dannet på udstyr i fødevareindustrien, hvis det ikke bliver rengjort ordentligt. Det er også rigtig skidt, fordi det kan betyde, at produktionen må standses og alt renses. Endelig er naturen også fyldt med biofilm, der bliver dannet på alt fra sten til andre overflader i for eksempel vand.
Da biofilm findes overalt og også spiller en enorm stor rolle i forskellige henseender, har forskere i mange år interesseret sig for biologien i biofilm. Hvad består en biofilm af, hvilke bakterier dominerer i biofilmen, og hvilke indbyrdes kampe findes der mellem de forskellige stammer af bakterier? Den slags spørgsmål er biologiske af karakter, men faktisk har de fysiske forhold i en biofilm også stor betydning for, hvordan en biofilm ser ud og fungerer. Netop det fysiske aspekt af en biofilm er det, som lektor Liselotte Jauffred fra DTU Bioengineering ved Danmarks Tekniske Universitet beskæftiger sig med.
»Det handler om at identificere “det andet” aspekt af biofilmdannelse og ikke kun belyse de biologiske eller kemiske faktorer, men også de fysiske. Forståelsen af de fysiske faktorer med indflydelse på biofilmdannelse vil gøre os klogere på, hvordan vi kan styrke biofilm de steder, hvor det giver mening, og hvordan vi kan hæmme biofilmdannelse de steder, hvor vi ikke vil have det,« forklarer hun.
Her finder du biofilm i dine omgivelser
Her finder du biofilm i dine omgivelser
I munden som tandplak:
Biofilm sidder som et klistret lag på tænderne og giver huller i tænderne samt tandkødsbetændelse, hvis det ikke børstes væk.
Kroniske sår som ved for eksempel diabetiske fodsår. Biofilm holder bakterierne fast i såret og gør dem sværere at slå ihjel. Det forsinker sårhelingen og kan kræve hyppig rensning.
Urinveje og katetre: Biofilm kan sætte sig på katetre og i urinvejene. Det giver tilbagevendende blærebetændelser og kan blokere katetre.
Lungerne som ved cystisk fibrose. Bakterier danner langvarige infektioner, som holder betændelsen i gang og langsomt forringer lungefunktionen.
Øre-næse-hals som ved mellemørebetændelse eller bihulebetændelse. Biofilm gør infektionen sejlivet, så symptomerne kommer igen og igen.
Hjerteklapper og blodkarproteser: På kunstige eller beskadigede overflader kan biofilm give alvorlige infektioner (endokarditis), som kræver langvarig behandling og ofte operation.
Kontaktlinser og øjeudstyr: Biofilm på linser eller etuier kan give øjenbetændelse og hornhindesår, hvis hygiejnen svigter.
Ortopædiske og andre implantater som kunstige hofter, skruer ved brækkede knogler eller pacemakere. Biofilm kan gøre infektioner meget svære at behandle og føre til, at implantatet må udskiftes.
Drikkevand og bygninger, for eksempel på brusehoveder, vandhaner og rør. Biofilm kan gemme på bakterier som Legionella sp. Det kan give dårlig lugt/smag på vandet, trykfald i rør og øget korrosion.
Hjemmets afløb, opvaskemaskine, kaffemaskine og tandbørste. Fugtige steder får hurtigt biofilm, som kan lugte og sprede bakterier, hvis man ikke rengør jævnligt.
Fødevareindustriens ståltanke, bånd og afløb. Biofilm kan forurene fødevarer med for eksempel Listeria monocytogenes, forkorte fødevarers holdbarhed og tvinge fabrikker til ekstra grundig rengøring.
Naturen: I vandløb og havet hjælper biofilm for eksempel med at nedbryde stoffer og holde stofkredsløbene i gang. Biofilm på skibsskrog kaldes biofouling og øger brændstofforbruget.
Spildevandsrenseanlæg: Her udnyttes biofilm positivt til at rense spildevand og fjerne forurening.
Bakterier opfører sig forskelligt i forskellige miljøer
En biofilm består af en række forskellige bakterier, der alle kæmper for at overleve og dele sig. Det sker i konkurrence med andre bakterier, og derfor foregår der reelt en krig i en biofilm, hvor de forskellige arter af bakterier på forskellige måder forsøger at bekæmpe hinanden og blive dominerende.
Nogle går i kamp med et arsenal af kemiske våben, mens andre beskytter sig selv ved at danne netværk af fibre og proteiner som et mikroskopisk beskyttelsesrum. Men der foregår også en masse samarbejde og arbejdsfordeling til alles bedste.
Det samlede resultat er komplekst patchworktæppe af forskellige bakterier i én stor koloni, hvor bakterierne indtager forskellige nicher i biofilmen og forsøger at holde fast på deres plads der.
Liselotte Jauffreds forskning går ud på at lave forsøgsopstillinger, hvor forskerne kan undersøge, hvordan forskellige aspekter af fysiske begrænsninger og mekanikken mellem bakterierne spiller en rolle for biofilmdannelsen og bakteriernes indbyrdes kamp. Hun forklarer, at det ikke er helt simpelt at studere bakterier i biofilm under “naturlige” forhold, og at det derfor kræver noget specielt af de anvendte forsøgsdesigns. For eksempel kan man godt studere interaktioner mellem forskellige bakterier i en væske i et reagensglas, men her vil de fysiske forhold slet ikke være de samme som i en biofilm.
Vil man undersøge for eksempel antibiotikaresistens hos givne bakterier i en biofilm og gør det ved at udsætte bakterier i et reagensglas for forskellige former for antibiotika, vil man med andre ord ikke kunne være sikker på svaret. En bakterieart kan nemlig sagtens være følsom over for et antibiotikum i et reagensglas, men helt og aldeles ufølsom overfor det i en biofilm. Der kan tætheden mellem bakterierne og deres matrix nemlig gøre, at antibiotikummet aldrig kommer i nærheden af bakterien.
Sammen med sine kolleger arbejder Liselotte Jauffred med bakterier i idealiserede modelsystemer, hvor hun farver bakterierne, så hun kan følge, hvordan de enkelte bakteriearter udvikler sig i kolonien eller biofilmen. Det vil sige, at bakterien X måske bliver farvet rød, Y blå og Z grøn. Forskerne kan derefter følge, hvordan de forskellige bakterier deler sig og bliver til flere eller færre over tid. De kan også se, hvordan de organiserer sig i den samlede biofilm, og hvad der sker i kontaktfladerne mellem de forskellige stammer af bakterier.
»Denne rumlige organisering er afgjort af bakteriernes gener, men også de fysiske forhold. I en væske kan bakterierne blive ved med at dele sig, så længe der er vækstmedie nok, men på en agarplade omgivet af andre bakterier kommer de fysiske begrænsninger for vækst i spil. Så har selve organiseringen indflydelse på, hvad generne kan få lov til at udtrykke,« siger Liselotte Jauffred.
Sådan danner bakterier en biofilm
Sådan danner bakterier en biofilm
En biofilm er et tyndt, klistret lag af mikroorganismer, der hæfter på en overflade og indlejrer sig i deres egen “lim”, som er en slags gel af polysakkarider, proteiner og DNA. Opbygningen af gelen starter, når overfladen først får et usynligt konditioneringslag af molekyler fra vand eller kropsvæsker. Pionerceller sætter sig efterfølgende fast på overfladen og begynder at udskille gelen, som virker som cement og forankrer bakterierne til overfladen. Cellerne deler sig i først små bakterieøer, der efterhånden forbindes til ét sammenhængende lag. I takt med, at flere bakterier kommer til, bliver biofilmen mere kompleks med større artsdiversitet og større funktionalitet. Biofilmen antager også en mere patchworkagtig struktur, hvor nogle dele af biofilmen fungerer på en måde, mens andre dele fungerer på en anden måde.
Fysisk er biofilmen kendetegnet ved at være viskoelastisk, hvilket vil sige at den både kan flyde lidt som en væske og samtidig har egenskaber som et elastisk materiale (på fagsproget siger man også, at biofilmen opfører sig som en blød hydrogel). De viskoelastiske egenskaber gør, at laget af biofilm kan tåle for eksempel strømninger i vand, vibrationer og tryk uden at slippe overfladen. Samtidig kan der over tid også dannes vandfyldte porer og kanaler i biofilmen, hvilket kan føre næring og oxygen dybere ind i laget af bakterier og affaldsstoffer ud.
Tykkelsen af en biofilm er typisk få til hundrede mikrometer, og der skabes gradienter gennem laget. Yderst er der mest oxygen og næring, mens der inderst er mindst. Det vil sige, at der gennem filmen bliver dannet forskellige lag, hvor forskellige bakterier kan udskære sig sin egen niche.
Biofilmens opbygning bremser også diffusion, så desinfektion og antibiotika trænger langsommere ind gennem lagene til bakterierne inderst inde. Bliver der revet flager af biofilmen, kan de føres videre i kroppen, i systemet eller i naturen og sætte sig fast et andet sted og starte nye biofilm. Overfladers ruhed, ladning og vandafvisning påvirker, hvor let biofilm dannes.
Bakteriers form giver en overlevelsesfordel i en biofilm
Et af Liselotte Jauffreds seneste forsøg var som eksempel med formålet at undersøge, hvordan en bakteries fysiske form har betydning for dens muligheder i en biofilm. En bakterie som colibakterien er stavformet, og det har betydning for, hvilken rolle den kan spille i en biofilm – uafhængigt af alle mulige biologiske forhold.
I forsøget undersøgte forskerne mutationer i colibakteriernes gener for dannelsen af cytoskelettet, der er med til at give colibakterien sin form. Disse mutationer gjorde blandt andet, at colibakterierne blev mere runde i formen og mistede deres stavformede struktur.
Efterfølgende lod forskerne både normale stavformede colibakterier og runde colibakterier danne en biofilm sammen og undersøgte så, hvordan formen havde betydning for deres individuelle organisering og overtag i biofilmen. Forsøget viste, at når bakterierne ikke længere var stavformede, groede de helt anderledes og dannede helt andre mønstre i biofilmen.
Forskernes egentlige spørgsmål var, om de runde eller stavformede bakterier ville vinde en kamp mellem de to i en biofilm, og hvordan den fysiske form havde betydning for udfaldet af denne kamp, hvis der indledningsvist havde været flere eller færre af den ene eller anden bakterie.
Forskningen viste, at det entydigt er en fordel for colibakterierne at være stavformede, når de skal leve i en biofilm. Det gjaldt både, når der var flere stavformede end runde bakterier til at starte med, og når der kun var ganske få stavformede bakterier fra begyndelsen af.
Liselotte Jauffred forklarer, at formen på bakterierne har betydning for, hvilke muligheder de enkelte colibakterier har.
Er bakterierne stavformede, kan de lægge sig parallelt med hinanden som blyanter i et penalhus, og det kommer med nogle fordele i en biofilm. Når bakterierne er stavformede, bliver de skubbet sammen i nogle kanaler, og de kanaler bevæger sig ud mod periferien af biofilmen, hvor der både er mere plads og bedre adgang til næringsstoffer sammenlignet med midt inde i biofilmen, hvor der både er pladsmangel og kamp om de få ressourcer derinde. Når de stavformede bakterier når ud til periferien af biofilmen, overtager de det område af biofilmen med mest plads og bedst adgang til næring, og over tid betyder det, at de fuldstændigt overtager dominansen i biofilmen.


»Laver man genetiske undersøgelser, kan det være svært at identificere, hvorfor den ene bakterie har bedre muligheder for at vokse i en biofilm sammenlignet med den anden. Det omtalte forsøg er et eksempel på, hvordan mekanikken mellem bakterierne er den afgørende faktor. Det viser også, hvorfor man ikke altid kan sammenligne det, som sker i et reagensglas, med det, som sker i en biofilm.
Lavede man det samme forsøg i et reagensglas, ville det være en fordel for bakterierne at være runde. Den slags forsøg har andre lavet, og der kan de se, at hvis man kører forsøget over flere år, vil flere bakterier udvikle sig mod at være runde, mens der over tid vil være færre stavformede bakterier. I en biofilm er det omvendt,« forklarer Liselotte Jauffred.
Bakterier beskytter hinanden mod antibiotika
Liselotte Jauffred laver med sine kolleger også andre forsøg, der belyser betydningen af forskellige aspekter af fysiske forhold for bakteriers vækstmuligheder i en biofilm. Blandt andet laver forskerne forsøg, hvor de undersøger, hvad der sker, når forskellige bakterier maser til hinanden for at få mere plads, hvilket sker i alle biofilm.
I starten vil bakterierne have rigeligt med vækstmuligheder, men i takt med at de nærmer sig hinanden, og pladsen bliver trang, skaber friktionen mellem bakterierne et fysisk stress inde i biofilmen. Dette kan lede til små udposninger eller rynker i biofilmstrukturen, og disse rynker har i sig selv betydning for de biologiske forhold i biofilmen, og hvad biofilmen som helhed kan og ikke kan.


En biofilm består heller ikke kun af bakterier, men også af forskellige molekyler, som de producerer. Forskerne laver også forsøg, hvor de genetisk manipulerer nogle bakterier til ikke at kunne producere disse molekyler, mens andre kan. Herefter undersøger de, hvad det betyder for de fysiske forhold inde i biofilmen, og hvordan det kan få nogle bakterier til at samarbejde for et fælles bedste.
Endelig undersøger forskerne også, hvordan de fysiske forhold i en biofilm har betydning for antibiotikaresistens. Det er måske det område, hvor forskningen åbner sig mest i retning af at være brugbar og ikke blot grundforskning. Antibiotikaresistens er nemlig et stort problem i hele verden, og forestiller man sig som eksempel, at der på en pacemaker eller et implantat bliver skabt en biofilm med bakterier, er det rart at have viden om, hvordan de udvikler resistens, og hvad man kan gøre ved det.
Forskning indenfor emnet har indtil videre kortlagt, at nogle bakterier er ganske følsomme over for antibiotika, når de svømmer rundt i en væske i et reagensglas, men overhovedet ikke er det i en biofilm. I den sammenhæng spiller de fysiske forhold en stor rolle, for eksempel når andre bakterier skaber nogle lommer i biofilmen, hvor antibiotika slet ikke kan nå. Det betyder, at selv følsomme bakterier i disse lommer kan være fløjtende ligeglade med, hvad vi mennesker forsøger at slå dem ned med. Sker det på overfladen af en pacemaker, har vi et problem.
»Nogle bakterier skaber fysiske lommer, hvor antibiotika ikke kan komme hen, mens andre renser omgivelserne for antibiotika, så det ikke kan have en effekt. Begge dele er eksempler på, hvordan fysiske forhold har betydning for antibiotikaresistens. Faktisk kan man bedre tale om antibiotikatolerance i miljøet, end man kan tale om decideret resistens. Større viden indenfor dette område kan hjælpe os i retning af at forstå, hvordan vi kan slå bakterier i biofilm ihjel og gøre det med mindst mulig brug af antibiotika,« siger Liselotte Jauffred.
Kan give mere viden om kræft
Endelig er Liselotte Jauffred også interesseret i at forstå, hvordan de fysiske interaktioner mellem bakterier har betydning for genoverførslen mellem individer af samme art og individer af forskellige arter. Her har den fysiske og rumlige organisering af bakterierne i biofilmen betydning for, om bakterierne overhovedet er i nærheden af hinanden til at kunne dele gener. Ved genoverførsel kan der igen være tale om overførsel af gener med betydning for antibiotikaresistens, så kan forskningen få betydning for, hvordan man vil bekæmpe bakterier i biofilm i fremtiden.
Liselotte Jauffred fortæller, at forskningen også har relevans for forståelsen af, hvordan fysiske forhold er med til at danne ikke bare biofilm, men også andre flercellede strukturer. Det kan dreje sig om flercellede bakteriekolonier, flercellede gærkolonier, flercellede planktonkolonier eller måske endda kræftsvulster, der også består af mange celler, som kæmper om den samme plads.
»Nogle af de fysiske mekanismer, som er til stede mellem individuelle bakterier i en bakteriekoloni, er også til stede mellem de individuelle celler i en kræftknude. Det er de samme fysiske kræfter, der er på spil, og derfor kan forståelsen af de fysiske kræfter mellem celler i en tæt bakteriekoloni gøre os klogere på biologi indenfor en helt masse områder,« siger hun. ♦